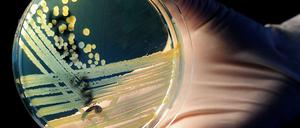
Europäische Behörden haben Samen aus Ägypten als mögliche Quelle des gefährlichen Ehec-Keims identifiziert. Ein Betrieb in Niedersachsen hat aus den Samen Sprossen hergestellt und vertrieben.

Die Stimmung auf dem Kairoer Tahrir-Platz erinnert an die Zeit unmittelbar vor dem Sturz Mubaraks. Diesmal fordern die Ägypter das Ende der Militärhoheit über das Land. Die Zukunft ist ungewiss.

Die Stimmung auf dem Kairoer Tahrir-Platz erinnert an die Zeit unmittelbar vor dem Sturz Mubaraks. Diesmal fordern die Ägypter das Ende der Militärhoheit über das Land. Die Zukunft ist ungewiss.
Rücktritt der Übergangsregierung, mehr als 30 Tote bei Protestdemonstrationen: Die Wut der Menschen in Kairo ist grenzenlos. Denn von der versprochenen Demokratie ist Ägypten noch immer weit entfernt.

Gut eine Woche vor Beginn der Parlamentswahlen eskaliert in Ägypten wieder die Gewalt. Am Wochenende gab es Tote und Verletzte bei Demonstrationen.

Was wird aus der Revolution in Nahost? Martin Gehlen und Katharina Eglau haben sie als unsere Korrespondenten miterlebt. Und meinen: Die Region ist auf Dauer verändert. Ein persönlicher Bericht aus nächster Nähe.
Die Berliner Comic-Zeichnerin Barbara Yelin war gerade fünf Wochen in Kairo, sie erlebte Rebellion und Alltag hautnah. Ihr Tagebuch in Bildern

Ägyptens Militärrat legt Verfassungsprinzipien fest und sichert seine Vormachtstellung. Das bringt Islamisten und Liberale gleichermaßen in Rage.
Mehr als 1200 Menschen waren an Bord der Fähre als ein Feuer ausbrach. Jetzt läuft die Rettung.
Der seit mehr als fünf Jahren verschleppte Soldat Gilad Schalit ist frei und wieder in Israel. Im Tausch gegen ihn entließ Israel mehrere hundert palästinensische Gefangene. Die deutsche Bundeskanzlerin Angela Merkel zeigte sich erleichtert.
Die Kopten in Ägypten fühlen sich mehr und mehr in die Enge gedrängt. Viele kehren ihrer Heimat den Rücken.
Der Politikberater Volker Perthes über die möglichen Attentats-Pläne des Iran, Risiken für den Arabischen Frühling und die Frage, warum Europa sich öffnen muss.
Nach den Angriffen auf Christen in Kairo wächst die Angst, dass das große Projekt Demokratie in Ägypten scheitern könnte.
Der Gewaltausbruch zwischen Christen und Muslimen stürzt Ägypten in die tiefste Krise seit dem Fall von Hosni Mubarak. Augenzeugen berichten von grausamen Szenen. Die Drahtzieher der Unruhen stammen offenbar aus den Reihen der früheren Mubarak-Schläger.
Bei schweren Ausschreitungen sind im Zentrum von Kairo Menschen umgekommen, Nachrichtenagenturen berichten von bis zu 21 Toten. Kopten hatten protestiert, weil eine Kirche niedergebrannt worden war.

Ägyptens Premier Essam Sharaf hält das Camp-David-Abkommen für "nicht sakrosankt". Der Streit um einen Palästinenserstaat verschärft sich.
Der türkische Ministerpräsident Recep Tayyip Erdogan besucht derzeit die Umbruchsstaaten in der arabischen Welt. Welche Botschaften überbringt er den Gastgebern?

Drei Tage tourt Recep Tayyip Erdogan nun durch den arabischen Frühling. Erst Kairo, dann Tunis und am Donnerstag Tripolis. Und dabei hat er ein klares Ziel.
In Kairo hat ein Mob die israelische Botschaft gestürmt, das Personal konnte in letzter Minute gerettet werden. Droht dadurch eine Destabilisierung in der Region?

Nach dem Sturm eines Mobs auf die israelische Botschaft in Kairo haben die Führungen von Ägypten und Israel am Wochenende versucht, den diplomatischen Schaden möglichst zu begrenzen.
Der plötzliche Gewaltausbruch in Kairo stellt die Beziehungen zwischen Israel und Ägypten auf eine harte Probe. Die ägyptische Übergangsregierung hat ihren Rücktritt angeboten. Nach dem Sturz der Mubarak-Regierung ringt das Land um Stabilität.
Die arabischen Länder bekommen für den Übergang zur Demokratie Hilfen von den größten Industrienationen der Welt. Ägypten, Tunesien, Marokko und Jordanien soll insgesamt 38 Milliarden Euro bekommen.
Beim Prozess gegen den früheren ägyptischen Präsidenten Mubarak liegen die Nerven blank. Anhänger und Gegner des Regimes misstrauen der Justiz und liefern sich Auseinandersetzungen.
Ein paar Kommentare in seinem Blog reichten, und Maikel Nabil Sanad wurde verurteilt. Vom Militär, das Demokratie versprochen hatte nach dem Sturz des Diktators. Nun trat er im Gefängnis in Kairo in einen Hungerstreik.
Nach den Terrorangriffen bei Eilat dreht sich die Spirale der Gewalt in der Region erneut. Israel erwägt auch eine Bodenoffensive im Gazastreifen.
Mord, Beteiligung an Mord und Bereicherung - so lautet die Anklage gegen Ägyptens Ex-Präsidenten Hosni Mubarak. Der Herrscher mit der eisernen Hand erschien am Mittwoch als gebrochener Mann vor dem Kairoer Gericht.
Am Rande des Prozesses gegen den gestürzten Präsidenten Hosni Mubarak ist es zu gewalttätigen Auseinandersetzungen zwischen seinen Anhängern und Gegnern gekommen. Der 83-Jährige selbst verfolgte den Prozess vom Krankenbett aus.

An diesem Mittwoch beginnt der Prozess gegen Ägyptens gestürzten Staatschef Mubarak – doch es gibt Zweifel, ob es dazu kommt.

Ausgerechnet in Kairo steht eine echte alte Walcker-Orgel – in einer evangelischen Kirche. Bald soll sie wieder erklingen.
Als Taher Elsaaidy diesen Januar zum Tahrir-Platz in Kairo aufbricht, ist er voller Hoffnung. Er feiert mit den Revolutionären. Dann treffen ihn drei Schüsse. Die Verletzung wird in Berlin versorgt.

Die Übergangsregierung hat am Samstagabend eine Demonstration mit Gewalt beendet. In der "Revolution Teil zwei" richtet sich der Volkszorn gegen die Armee, die ihre neu erlangten Machtprivilegien nicht mehr abgeben will.

Umbruch in Nahost: Nach den spektakulären Volkstriumphen in Tunesien und Ägypten wird die Orientierung schwieriger, die revolutionäre Fahrt stockt. Nach einem halben Jahr eine erste Bilanz unseres Korrespondenten.

Immer mehr Menschen zweifeln, ob der herrschende Militärrat es wirklich ernst meint mit dem Weg in die Demokratie. Stattdessen mehren sich die geheimen Militärprozesse gegen Zivilisten.
Neue Erkenntnisse auf der Suche nach der Quelle des gefährlichen Ehec-Keims: Bockshornkleesamen aus Ägypten sollen die Epidemie ausgelöst haben.

Fast ein halbes Jahr nach dem Sturz Mubaraks stürmen unzufriedene Jugendliche wieder den Tahrir-Platz. Sie sind über den Gang der Dinge nach ihrer "Revolution" enttäuscht.

Sechs Tage die Woche öffnet Ägypten die Grenze zu Gaza. Frauen und Kinder können passieren, junge Männer brauchen erst ein Visum. Rafah hat das einzige Tor zum Gazastreifen, das nicht von Israel kontrolliert wird.

Ägypten und Tunesien können bei ihrem demokratischen Aufbruch auf milliardenschwere Hilfen der Weltgemeinschaft bauen. Die G-8-Länder wollen die nordafrikanischen Reformstaaten unterstützen.

Sie verfolgen christliche Kopten und feiern Al Qaida: Die radikalislamische Gruppe der Salafisten entwickelt sich in Ägypten zur politischen Gefahr.
SPD-Chef Sigmar Gabriel trifft in Berlin Protest-Aktivisten aus der arabischen Welt und will dabei vor allem zuhören. Das ist gut, denn so erfährt er, dass die Arabische Revolution Unterstützung von oben bekam.

Der Umbruch in Tunesien und Ägypten bringt die Reisebranche unter Druck. Die Preise sind um bis zu 40 Prozent gesunken.
Ägypten fährt einen neuen Kurs. Kaum aber hatte das Land begonnen, seine alte außenpolitische Route zu verlassen, schlagen in der Region die Wellen hoch. Dabei wirken die Drehungen am diplomatischen Steuerrad zunächst nicht besonders spektakulär.
Auf dem Nil im Süden Ägyptens ist eine Fähre gekentert. Dutzende Menschen kamen dabei ums Leben.
öffnet in neuem Tab oder Fenster